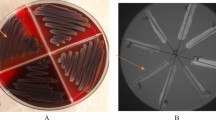

Abstract
Klebsiella pneumoniae is an important opportunistic pathogen causing community-acquired and hospital-acquired infections. This aim of this study was to analysis the antibiotic-resistance phenotypes, carbapenemase genes, virulence genes, and genotypes the 62 K. pneumoniae clinical isolates, and to explore the correlations between these isolates. The antimicrobial susceptibility profiles were determined using the BD Phoenix-100 system. Carbapenemase and virulence genes were detected using multiplex PCR. Out of the 62 K. pneumoniae clinical isolates, 79.0% were exhibited resistance to antibiotics, with 69.4% displaying multi-drug resistance. The rate of antibiotic-resistance was highest for penicillin (71.0%), followed by cephalosporins (66.1%), and lowest for carbapenems (29.0%). The detection rates of carbapenemase genes were as follows: KPC (56.5%), VIM (35.5%), and NDM (1.61%). Additionally, seven virulence genes were detected with the highest prevalence rates, of which entB and mrkD were at the top of the carrier rates with 95.2% each. The study classified 62 isolates into 13 clusters and 46 genotypes using ERIC-PCR. Cluster A6 exhibited the highest genetic diversity, comprising 20 strains and 13 genotypes. The statistical analysis revealed a strong correlation between MDR and resistance to penicillin and cephalosporin. Furthermore, genes related to siderophores were closely associated with mrkD. Genotypes identified by ERIC-PCR showed a negative correlation with allS. The study revealed a negative correlation between antibiotic resistance and genes kfu, ybtS, iutA, rmpA, and allS. Conversely, a positive correlation was observed between antibiotic resistance and genes entB and mrkD. The correlations identified in this study provide insights into the occurrence of hospital-acquired infections. The findings of this study may guide the prevention and control of K. pneumoniae outbreaks by utilizing appropriate medication.
Similar content being viewed by others
Avoid common mistakes on your manuscript.
Introduction
Klebsiella pneumoniae is a commonly encountered opportunistic pathogen in hospital-acquired infections, capable of causing bacteremia, urinary tract infections (UTIs), pneumonia, pyogenic liver abscesses, burns, and wound infections [1]. The hypervirulent variant of K. pneumoniae (hvKp) was initially identified in Taiwan in the 1980s. This strain represented a new variant of K. pneumoniae linked to severe invasive and metastatic diseases [2]. Infections induced by hvKp are often linked to pyogenic liver abscesses. Some researchers posit that strains exhibiting hypermucoviscosity (HMV) play a pivotal role in defining hvKp due to this association [3, 4]. The presence of virulence factors in bacteria may correlate with disease severity. The HMV phenotype of hvKp has been attributed to the carriage of a virulence plasmid that harbours two CPS regulator genes (rmpA and rmpA2) and a number of siderophore gene clusters (entB, kfu, iutA, ybtS), biofilm (mrkD) and allantoin metabolism (allS) genes also contribute to the virulence of K. pneumoniae, and the functions of genes has been shown in Table 1 [5].
MDR K. pneumoniae is regarded as a significant public health concern due to the limited efficacy of antibiotic options [6]. Carbapenems are frequently used as a final resort for treating infections caused by drug-resistant organisms, especially K. pneumoniae, due to their extensive antibacterial properties and resistance to β-lactamases. Both beta-lactamases and mutations in outer membrane proteins (OMPs) contribute to bacterial resistance against β-lactams, such as cephalosporins, penicillin, and carbapenems. The carbapenemase genes (KPC, VIM, IMP, NDM and OXA) have different hydrolyzing functions for antibiotics and the functions of genes has been shown in Table 1.
Understanding the genetic characteristics and diversity of K. pneumoniae is crucial for comprehending the transmission, evolution, and control of infections. The ERIC-PCR method is a rapid, reliable, and cost-effective approach used for molecular typing of the Enterobacteriaceae family, specifically to analyze the genetic linkage among K. pneumoniae clinical isolates [7]. Utilizing ERIC fingerprinting of clinical isolates provides valuable insights into the origins and characteristics of infections, thereby facilitating the effective management of nosocomial infections.
This study aims to explore the phylogenetic grouping, antimicrobial resistance, carbapenemase genes and virulence genes of clinical K. pneumoniae isolates collected from hospitalized patients in Guangdong, China, and the association between these factors was evaluated via statistical analysis. Our results will provide valuable epidemiological knowledge and may help to establish effective measures for the future prevention and management of K. pneumoniae in hospitals.
Materials and Methods
Bacterial DNA Extraction
A total of 62 non-duplicated isolates were collected from patients at a hospital located in Guangzhou, China. All bacterial isolates have been identified as K. pneumoniae using the VITEK 2 system (BD Diagnostics, France) [8]. The isolates were activated and incubated at 37 ℃. Individual colony was picked and mixed with 100 µL of sterile distilled water, heated at 100 ℃ for 20 min, and centrifuged at 10,000 g for 5 min to collect the DNA supernatant, which was stored at −20 ℃ for use [9].
Testing for String and Antimicrobial Susceptibility
Fresh colonies were cultured overnight on blood agar plates and gently streaked outward using an inoculating ring. If mucus filaments were observed and their length exceeded 5 mm, the strains were classified as positive for the hypermucoviscous phenotype [10].
The antimicrobial susceptibility profiles of the 62 K. pneumoniae clinical isolates were determined using the Phoenix-100 system (BD Diagnostics, France) [11]. The results were interpreted based on the minimal inhibitory concentration (MIC) interpretive standards of the Clinical and Laboratory Standards Institute (CLSI) 2023 [12]. The tested antimicrobial agents have been included in Table 2.
Detection of Carbapenemase Genes
The presence of five carbapenemase-encoding genes were detected in 62 K. pneumoniae isolates using multiplex PCR with five primers pairs [13].The reaction I included primers for IMP and VIM. Reaction II contained primers for KPC, NDM and OXA. The primer sequences were provided in Table 3, the PCR systems were presented in Table 4 and the PCR reaction conditions for reactions were presented in Table 5.
Detection of Virulence Genes
The presence of seven virulence genes was detected in 62 K. pneumoniae isolates using multiplex PCR gene primers [14]. Reaction III included primers for iutA, kfu, and entB, while Reaction IV included primers for allS, rmpA, mrkD, and ybtS. The forward and reverse primers quality and sequences are listed in Table 3 and the PCR systems were presented in Table 4, the PCR reaction conditions for reactions were presented in Table 5.
ERIC-PCR Genotyping
The primers used in this study were performed as described in the reference [15] and designed according to the target gene sequences published in GenBank (http:/www.ncbi.nlm.nih.gov/genbank/). ERIC-PCR was conducted on 62 K. pneumoniae clinical isolates using the ERIC-F (ATGTAAGCTCCTGGGGATTCAC) and ERIC-R (AAGTAAGTGACTGGGGT-GAGCG) primers. The PCR systems and reaction conditions are detailed in Table 3 and Table 4, respectively. The samples were then stored at −4 ℃.
Amplicons were separated in a 1.0% (w/v) agarose gel, visualized, and photographed under UV illumination. The ERIC-PCR fingerprint was analyzed using Quantity One software (Bio-Rad, America). A UPGMA dendrogram was constructed using NTsys-pc 2.1 software for phylogenetic analysis. A strain was considered part of the same cluster if its banding pattern similarity was exceeded 80% [16].
Statistical Analysis
Statistical analysis was performed using SPSS version 26.0. The association between categorical variables was assessed using both the Chi-square (χ2) test and Fisher’s exact test. The isolates were subjected to examination for resistance phenotypes, resistance genes, and virulence genes. Positive results were genotyped based on the same clusters as a criterion for data analysis. Finally, the potential correlations between the genotype, virulence gene, carbapenemase gene, and antibiotic resistance phenotypes of 62 clinical isolates of K. pneumoniae were assessed using Spearman’s correlation analysis. Bivariate correlation analysis was used to calculate correlation coefficients, denoted as ρ. A positive ρ indicates a positive correlation, a negative ρ indicates a negative correlation, and ρ = 0 indicates no correlation. The magnitude of ρ determines the strength of the correlation. A p value of less than 0.05 was considered statistically significant. The correlation plot was generated using TBtools, a toolkit that integrates multiple biological data-handling tools for biologists.
Results
Hypermucoviscous Phenotype and Antibiotic-Resistance
Eight out of the 62 clinical isolates of K. pneumoniae, which showed a high mucus phenotype in the string test (KP56, KP39, KP18, KP26, KP50, KP51, KP28, and KP11), all formed mucoid linear chains longer than 5 mm. These isolates were in agreement with the findings of the subsequent virulence gene test.
Out of the 62 strains tested, 13 (21.0%) displayed susceptibility to all antibiotics, while the remaining 49 (79.0%) strains exhibited multiple antibiotic-resistance phenotypes (Fig. 1). Of the strains tested, 43 (69.4%) exhibited multidrug resistance (MDR), 16 (25.8%) were resistant to 6 antibiotic classes, 10 (16.1%) demonstrated resistance to 15 antibiotics, and 4 (6.5%) were resistant to only one antibiotic. The resistance rates of the 15 antibiotics varied significantly. Eight antibiotics, namely PIP (69.4%), CZO (66.1%), CTX (66.1%), SAM (64.5%), FEP (62.9%), STX (54.9%), LVX (51.6%), and CIP (50.0%), exhibited resistance rates exceeding 50%. In addition, GEN (48.4%), CAZ (45.2%), CSL (38.7%), and TZP (38.7%) showed high levels of resistance, around 40%. AMK, IPM, and MEM were identified as the most effective antibiotics against the isolates, with the lowest resistance rate (29.0%). The clinical isolates showed the highest resistance rate to penicillin (44, 71.0%), followed by cephalosporins (41, 66.1%), fluoroquinolones (36, 58.0%), sulphonamides (34, 54.8%), aminoglycosides (30, 48.4%), and carbapenems (18, 29.0%). A total of 28 distinct antibiotic-resistance phenotypes were observed among the 62 isolates, with each isolate exhibiting resistance to one or more of the 15 antibiotics included in the study. Significant variation was observed in the distribution of isolates across these combinations. For example, a27 was present in 10 isolates, while a2, a4, and a5 were each found in one isolate.
Resistance rates (%) of the 62 clinical isolates of K. pneumoniae to 15 selected antibiotics. 15 antibiotic abbreviations are listed on the left; blank cells: antibiotic sensitive, color cells: antibiotic resistant; a1–a28: 28 resistance phenotypes to 15 antibiotics in 62 isolates; n number of isolates with the same antibiotic resistance
The Presence of Carbapenemase and Virulence Genes
The PCR results obtained from the 62 clinical isolates demonstrated the presence of carbapenemase genes in 41 (66.1%) strains, virulence genes in 60 (96.8%) strains, and the absence of both carbapenemase and virulence genes in 2 (3.2%) strains (Fig. 2). Among the 41 isolates that produced a carbapenemase, three different carbapenemase genes were identified in this study: KPC (35, 56.5%), VIM (22, 35.5%), and NDM (1, 1.6%), however, IPM and VIM genes were not detected in any of the strains. The classification of the 41 strains carrying carbapenemase genes identified two categories: 24 strains carry either the KPC or VIM genes, while 17 strains carry both genes.
Prevalence of 3 carbapenemase genes and 7 virulence genes among 62 clinical isolates of K. pneumoniae. The 3 resistance genes and 7 virulence genes are listed on the left; blank cells: not gene-negative, color cells: gene-positive; b1–b26: 26 combinations of 10 positive genes in 62 isolates; n number of isolates with the same positive gene
Among the 60 isolates carrying virulence genes, a total of 7 distinct virulence genes were identified. Each isolate showed the presence of at least 2 virulence genes, with 4 isolates demonstrating the presence of all 7 virulence genes. All 60 isolates showed the presence of siderophore-associated genes, with each isolate carrying at least one of the four genes (entB, kfu, iutA, ybtS). Of the 62 clinical isolates, the highest detection rates were for entB and mrkD (95.16% each), followed by ybtS (54.84%), kfu (25.81%), iutA (16.13%), rmpA (12.90%) and the lowest rate was for allS (9.68%).
Among 26 combinations of 10 positive genes, the combination ‘b8’ exhibited the highest detection rate at 21.0%. Out of these combinations, only one isolate carried all 10 positive genes. Additionally, entB, mrkD, and KPC showed a high simultaneous detection rate, not only in separate combinations as ‘b3’, but also as part of other combinations in 29 other isolates, including b5, b7, and others. Notably, b3 was the most common gene combination, surpassing b8.
Statistical Analysis of Genes and Resistance Phenotypes
A statistical analysis was conducted on 49 clinical isolates of K. pneumoniae that showed antibiotic resistance. The isolates were categorized into two resistance phenotypes: MDR (resistant to three or more antibiotics) and R (resistant to one or two antibiotics). The aim of the analysis was to investigate the correlation between two resistance phenotypes and the presence of carbapenemase genes and virulence genes. Table 6 shows the results among the resistant isolates: 30 (61.2%) isolates were positive for at least one carbapenemase gene, with 26 (53.1%) having KPC, 17 (34.7%) VIM, and only one (1.61%) NDM. Notably, none of the isolates exhibited resistance to the tested antibiotics. When considering the 47 isolates that tested positive for virulence genes out of the 49 resistant strains, the prevalence of specific genes was as follows: entB was present in 47 isolates (96.0%), mrkD in 46 isolates (93.9%), ybtS in 24 isolates (49.0%), kfu in 13 isolates (26.5%), iutA in 6 isolates (12.2%), rmpA in 5 isolates (10.2%), and allS in 4 isolates (8.2%). Notably, only the ybtS gene showed a statistically significant difference (p < 0.01). Furthermore, the KPC, VIM, iutA, rmpA, and allS genes were identified exclusively in MDR strains, whereas the entB, kfu, ybtS, and mrkD genes were found in both the MDR and R strains. The presence or absence of carbapenemase genes showed a significant association with resistance phenotypes (p < 0.001). Additionally, the presence of a single carbapenemase gene was significantly linked to the resistance phenotypes (p < 0.05).
ERIC-PCR Analysis
The ERIC-PCR band pattern analysis of 62 K. pneumoniae isolates revealed 13 distinct clusters and 46 ERIC-PCR genotypes at an 80% similarity level (Fig. 3). The Simpson’s index of diversity (SID) for ERIC was 0.988. Among these clusters, 8 were clonal types and 5 were monotypes. Clonal clusters A4, A5, A6, A7, A8, A10, A12, and A13 represented 41 ERIC genotypes and 57 isolates. In contrast, monotypes A1, A2, A3, A9, and A11 each had a single genotype and strain. Among the 8 clonal clusters, A6 showed the highest genetic diversity with 13 genotypes and 20 strains. A7 had 9 genotypes and 15 strains, A8 had 5 genotypes and 8 strains, and A5 had 6 genotypes and 6 strains. Clusters A4, A10, A12, and A13 each contained 2 genotypes and 2 strains.
ERIC-PCR fingerprinting and UPGMA clustering of 62 K. pneumoniae clinical isolates. The clustering tree is displayed on the left side, with the top axis representing the degree of similarity. The similarity is bounded by 0.8 (80%), more than that means strains belongs to the same cluster. There are a total of 13 clusters, labelled as A1–A13. In the middle, the ERIC-PCR electropherogram is shown. On the right side, the genotyping results are presented, including strain numbers (KP1–KP62), 28 antibiotics resistance of 15 antibiotics in 62 isolates (R–p, a1–a28, Fig. 1), and 26 combinations of isolates with the same positive gene (C–V, b1-–b26, Fig. 2)
Correlations Analysis
According to Spearman’s correlation analysis (Fig. 4), positive correlations of varying strength were observed between the different antibiotic resistance phenotypes. The analysis revealed a strong positive correlation between penicillin resistance and multidrug resistance (MDR) (ρ = 0.859, p < 0.001) and between cephalosporin resistance and MDR (ρ = 0.819, p < 0.001). The presence of the carbapenemase gene also demonstrated positive correlations with both MDR (ρ = 0.428, p < 0.001) and CeR (ρ = 0.476, p < 0.001). Furthermore, a strong positive correlation was observed between the siderophore-associated gene and mrkD (ρ = 0.810, p < 0.001) and a positive correlation between rmpA and allS (ρ = 0.688, p < 0.001). Moreover, ERIC genotyping demonstrated a positive correlation with fluoroquinolone resistance (ρ = 0.566, p < 0.001) and the siderophore-associated gene (ρ = 0.474, p < 0.001), but a negative correlation with allS (ρ = −0.304, p = 0.016). The statistical analysis showed a perfect positive correlation (ρ = 1) between the carbapenemase gene and the siderophore-associated gene. The hypermucoviscous phenotype demonstrated a negative correlation with all parameters except allS, which exhibited a positive correlation. However, none of these correlations were statistically significant (p > 0.05). ERIC genotyping and some antibiotic resistance phenotypes showed positive correlations with certain virulence genes. Our analysis showed a positive correlation between antibiotic resistance phenotypes and carbapenemase-like genes, in accordance with the results presented in Table 6.
Heatmap of 62 K. pneumoniae clinical isolates with hyper viscosity phenotypes, antibiotics-resistance phenotypes, carbapenemase genes, virulence genes, and ERIC correlation matrices for different parameters. Red indicates positive correlations, while blue indicates negative correlations between different parameters. Abbreviation: HMV hypermucoviscous phenotype, MDR multi-drug resistance, CeR cephalosporin resistance phenotype, AR aminoglycoside resistance phenotype, CR carbapenem resistance phenotype, SR sulphonamide resistance phenotype, FR fluoroquinolone resistance phenotype, PR penicillin resistance phenotype, C–g carbapenemase gene, S–a siderophore-associated gene, ERIC, ERIC-PCR genotyping
Table 6 and Fig. 4 indicate that there was no statistically significant relationship between antibiotic resistance phenotypes and virulence genes. However, a tendency towards a negative correlation was observed. A correlation analysis was performed on each of the 15 antibiotic resistance phenotypes and 7 virulence genes after fully expansion. Figure 5 shows that most of the correlations observed between antibiotic resistance and virulence genes were negative. The correlation analysis revealed that antibiotic resistance was negatively correlated with most iron transporter genes, such as STX with ybtS, CIP with kfu, and PIP with iutA (p < 0.05). Furthermore, the non-iron transport genes rmpA and allS were also negatively associated with antibiotic resistance, respectively (p < 0.05). Only entB, an iron transport gene, showed a positive correlation with SAM. Additionally, both mrkD with CZO and allS with CAZ exhibited a positive correlation (p < 0.01).
Heatmap of the correlation between antibiotics and virulence genes in 62 clinical isolates of K. pneumoniae. The red indicates a positive correlation, while the green indicates a negative correlation between different parameters. The 15 antibiotics are listed in descending order of resistance rate from top to bottom, and the 7 virulence genes are listed in descending order of detection rate from left to right
Discussion
Antimicrobial resistance (AMR) has emerged as one of the most significant public health threats of the twenty-first century. It is estimated that AMR could result in the deaths of 10 million individuals annually by 2050 [17]. The rapid emergence and spread of hypervirulent and MDR K. pneumoniae isolates represent a significant concern in clinical settings. In recent years, K. pneumoniae has demonstrated significant resistance to β-lactam, aminoglycoside, and quinolone antibiotics. The prevalence of MDR and pan-drug-resistant (PDR) K. pneumoniae is increasing [18]. According to CHINET data, K. pneumoniae strains have a relatively high rate of resistance to penicillin and most cephalosporins [19]. The resistance results for each of the 6 antibiotic classes are presented in Fig. 1. The highest resistance rate was observed for cephalosporins and the lowest for carbapenems. Nevertheless, our findings were less pronounced than those reported by Remya in 2019 in India, where the resistance rate was 87.8% [20]. A comparison of our findings with those of other studies revealed that resistance rates for carbapenems were similar (25%), whereas those for cephalosporins were considerably higher (> 90%) [21].
The main cause of carbapenem resistance in K. pneumoniae is the production of carbapenemases, especially KPC and IMP, in China. However, our findings regarding carbapenemase genes showed a slight discrepancy. Among the 62 isolates, 66.1% (41/62) carried carbapenemase genes. The most prevalent was KPC (35, 56.5%), followed by VIM (22, 35.5%) and NDM (1, 1.6%). No IMP or OXA genes were detected (Fig. 2). A total of 3.2% (2/62) of the isolates did not carry any of the carbapenemase and virulence genes examined. These isolates may have carried genes that were not included in the PCR analysis. The analysis revealed that among the isolates carrying the carbapenemase gene, resistance to carbapenems was relatively low, at 34.1%. In contrast, the highest level of resistance was observed for penicillin, at 70.7% (29/41), followed by cephalosporins at 63.4%. These findings suggest that the extensive use of penicillin and cephalosporin in this hospital has led to a significant level of resistance to K. pneumoniae. The study identified a correlation between the presence of carbapenemase genes and drug resistance (Table 6). The study highlights the importance of strict control and management of carbapenem use in treating clinical infections. Out of 41 isolates identified, 18 were found to be resistant to carbapenemase. However, only 14 isolates exhibited both matching carbapenemase genes and resistance to carbapenem. Consequently, the presence of a carbapenemase gene does not necessarily indicate its expression. Two main reasons can explain this phenomenon. Firstly, Firstly, the failure to express other carbapenem-resistant genes may be due to regional genetic variations in the carbapenemase gene, posing challenges in identifying resistant strains at the molecular level. Another reason for the increased prevalence of CRKP is the presence of strains with alternative carbapenem-resistant mechanisms, such as the deletion of outer membrane pore proteins, mutant deletions, or abnormal overexpression of efflux pump systems. A study at a tertiary care hospital in China found that 23% of the 217 CRKP clinical isolates were identified with bla OXA-48-like genes [22]. The detection rate of carbapenemase genes in our study is lower than the rate reported in [23].
The 2022 China antimicrobial surveillance network (CHINET) report indicates that K. pneumoniae has consistently been the second most commonly reported pathogen (14.1%) in clinical infections, with its incidence increasing annually [24]. Epidemiologists have increasingly focused on hvKP, a variant of K. pneumoniae, due to its highly invasive nature. Over three decades ago, studies indicated that rmpA was associated with the virulence and mucoid phenotypes of K. pneumoniae [25]. Additionally, it has been found that rmpA stimulates the synthesis of extracellular polysaccharides, resulting in a highly mucoviscous phenotype in cells of various serotypes of K. pneumoniae [26]. In our study, we identified virulence genes in 8 HMV isolates and 62 isolates. The number of virulence genes detected in strains categorized under the two groups mentioned above were as follows: entB (7 & 59), ybtS (4 & 34), kfu (3 & 16), iutA (2 & 10), mrkD (7 & 59), rmpA (2 & 8), and allS (2 & 6). Notably, discrepancies were observed between the 8 hypermucoviscous strains and rmpA. The absence of a noticeable hypermucoviscous phenotype in the 6 isolates with rmpA but not HMV strains could be attributed to loss of activity in the rmpA genes caused by point mutations or small deletions/insertions [4]. An alternative hypothesis is that rmpA is repressed by Fur regulation of the capsular polysaccharide biosynthesis and iron acquisition systems [27]. A high frequency of entB, in conjunction with glycolate activation and iron uptake systems, was observed, supporting the second possibility and indicating that the K. pneumoniae isolates in this study have a robust ion trapping capacity [28]. Our assay results also showed that mrkD has a high occurrence rate similar to entB. The genetic code governs the production of fimbriae adhesins that bind to the extracellular matrix, leading to biofilm formation that offers protection against both the host immune response and antibiotics [29]. A previous study offers an explanation for the discrepancy between the mrkD and string test results. The researchers found that isolates expressing hypermucoviscous traits and harboring the mrkD and fimH genes, responsible for type 3 and type 1 fimbriae, respectively, showed reduced initial adhesion because of a hypercapsule that could mask these fimbriae [30]. Additionally, we observed the presence of allS in K. pneumoniae, which enables the utilization of nitrogen as an energy source in both aerobic and anaerobic conditions. Our study results indicate that allS is responsible for anaerobic nitrogen assimilation from allantoin. Previous studies with similar phenotypic outcomes have demonstrated that the entB, ycfM, and mrkD genes are most prevalent among virulence-associated genes in K. pneumoniae isolates [31]. Similarly, in Mahsa’s study, mrkD was the most common gene in all 60 strains, followed by entB and ybtS [32]. A study at a Chinese hospital found that ybtS had the highest occurrence of virulence factors (95.2%, 20/21), followed by iutA (90.5%, 19/21), and iuc (57.1%, 12/21) [10]. In Sudan, Albasha identified K. pneumoniae isolates from hospitalized neonates and adults in Khartoum State. The most prevalent virulence gene was entB (93.3%), followed by mrkD (78.3%) and kfu (60%) [33]. The study reported that allS was detected in 12% of K. pneumoniae isolates obtained from diverse food samples in Al-Diwaniyah City, Iraq [34].
The results of the string testing showed that isolates with the mucilage phenotype were mainly found in clusters A6 and A7 (3 plants each), while the remaining isolates were in clusters A8 and A12 (1 plant each). Statistical analysis indicated that A7 had the highest number of antibiotic-resistance cases, with 11 instances (a1, a3, a5, a7, a8, a10, a21, a22, a24, a26, a28), followed by A6 with 9 cases. A6 and A7 had the most positive gene combinations, each with 12 (A6: b1, b2, b5, b7, b8, b12, b17, b18, b21, b20, b23, b25; A7: b2, b4, b5, b7, b8, b10, b11, b13, b17, b19, b21, b24). Among the isolates, 83.9% (52/62) had identical gene clusters, and carbapenemase genes, virulence genes, and antibiotic-resistance phenotypes were also identical in 69.4% (43/62), 64.5% (40/62), and 38.7% (24/62) of cases, respectively. Furthermore, when genotypes were identical, the corresponding percentages of identical carbapenemase genes, virulence genes, and antibiotic-resistance phenotypes were 9.7% (6/62), 6.5% (4/62), and 6.5% (4/62), respectively. These findings align with previous correlation analyses linking ERIC-PCR with resistance phenotypes (specifically fluoroquinolone resistance) and virulence genes (specifically siderophore-associated gene and allS) (Fig. 4). Previous research has demonstrated the role of siderophores in the virulence of various bacterial pathogens. Molecular epidemiological studies have also shown a higher prevalence of iron carrier-related genes in highly virulent K. pneumoniae strains compared to carbapenem-resistant K. pneumoniae strains [35]. Additionally, our findings indicate a strong positive correlation between carbapenemase genes and siderophore-associated genes, implying a potential confounding factor in these results. Wasfi conducted a study to explore the relationships among genotyping methods, resistance phenotypes, and virulence genes of K. pneumoniae [36]. Further statistical correlation analyses revealed a significant link between ERIC-PCR genotyping and virulence genes, resistance genes, and resistance phenotype.
The relationship between antimicrobial resistance and virulence can be either negative or positive, indicating that they are not independent characteristics. Anti-virulence compounds are being increasingly employed to manage the rise and dissemination of antibiotic-resistant strains [48]. Experimental data revealed a correlation between 7 virulence genes and resistance to 15 antibiotics. Upon examination based on antibiotic categories, both penicillin and cephalosporins were linked to the 4 virulence genes depicted in Fig. 5. They also exhibited negative correlations with iutA, rmpA, and allS. Penicillin showed a positive correlation with entB, while cephalosporins showed a positive correlation with mrkD. Importantly, there is a predominantly negative correlation between antibiotic resistance and iron transporter genes. Sulfonamides showed a negative correlation only with ybtS, while fluoroquinolones, aminoglycosides, and carbapenems all exhibited a negative correlation with kfu. This finding aligns with prior studies, indicating that closely related strains often share similar resistance and virulence genes.[37]. Negative correlations were observed between the presence of virulence genes (hlyA and prfA) and antimicrobial resistance [38]. A significant association was found in Sichuan Province between the presence of most virulence genes and ESBL genes [39]. Chen found no significant correlation between the distribution of virulence genes and the type of infection [40].
Conclusion
The study revealed that carbapenem antibiotics were more effective against K. pneumoniae, while cephalosporins and penicillin were mostly resistant. The K. pneumoniae isolates identified in these clinical samples exhibited high virulence and substantial multidrug resistance. Identifying negative correlations between the majority of iron transport genes and antibiotic resistance, suggests that detecting iron transport genes could offer crucial insights for clinical antibiotic treatment and MDR K. pneumoniae prevention. One limitation of the current study is the relatively small sample size, which reduces the generalisability of the results. Nevertheless, the findings can serve as valuable references for future research.
Code
Not applicable.
Data Availability
Data available on request from the corresponding author.
References
Liao YQ, Gong JW, Yuan XL et al (2023) (2023) Drug resistance genes and molecular epidemiological characteristics of Carbapenem-resistant Klebsiella pneumonia. Infect Drug Res 16:1511–1519. https://doi.org/10.2147/idr.S399142
Cheng DL, Liu YC, Yen MY et al (1991) Their association with Klebsiella pneumoniae bacteremia in diabetic patients. Arch Intern Med 151(8):1557–1559. https://doi.org/10.1001/archinte.1991.00400080059010
Alcántar-Curiel MD, Girón JA (2015) Klebsiella pneumoniae and the pyogenic liver abscess: implications and association of the presence of rpmA genes and expression of hypermucoviscosity. Virulence 6(5):407–409. https://doi.org/10.1080/21505594.2015.1030101
Yu WL, Lee MF, Tang HJ et al (2015) Low prevalence of rmpA and high tendency of rmpA mutation correspond to low virulence of extended spectrum β-lactamase-producing Klebsiella pneumoniae isolates. Virulence 6(2):162–172. https://doi.org/10.1080/21505594.2015.1016703
Paczosa MK, Mecsas J (2016) Klebsiella pneumoniae: Going on the Offense with a Strong Defense. Microbiol Mol Biol Rev 80(3):629–661. https://doi.org/10.1128/mmbr.00078-15
Hou XH, Song XY, Ma XB et al (2015) Molecular characterization of multidrug-resistant Klebsiella pneumoniae isolates. Braz J Microbiol 46(3):759–768. https://doi.org/10.1590/s1517-838246320140138
Barus T, Hanjaya I, Sadeli J et al (2013) Genetic diversity of Klebsiella spp. isolated from tempe based on enterobacterial repetitive intergenic consensus-polymerase chain reaction (ERIC-PCR). HAYATI J Biosci. 20(4):171–176. https://doi.org/10.4308/hjb.20.4.171
El Sherif HM, Elsayed M, El-Ansary MR et al (2022) BioFire FilmArray BCID2 versus VITEK-2 system in determining microbial etiology and antibiotic-resistant genes of pathogens recovered from central line-associated bloodstream infections. Biology 11(11):1573. https://doi.org/10.3390/biology11111573
Kong NQ, Shu SH, Zhang CY et al (2023) Intergenic region polymorphism analysis: a novel genotyping method for Klebsiella pneumoniae. J Appl Microbiol 134(3):1–10. https://doi.org/10.1093/jambio/lxad030
Zhan L, Wang S, Guo Y et al (2017) Outbreak by Hypermucoviscous Klebsiella pneumoniae ST11 isolates with Carbapenem resistance in a Tertiary Hospital in China. Front Cell Infect Microbiol 7(182):1–9. https://doi.org/10.3389/fcimb.2017.00182
Zhou M, Wang Y, Liu C et al (2018) Comparison of five commonly used automated susceptibility testing methods for accuracy in the China antimicrobial resistance surveillance system (CARSS) hospitals. Infection Drug Resistance 11:1347–1358. https://doi.org/10.2147/idr.S166790
Sumit R, Debabrata D, Nidhima A (2023) Introducing the new face of CLSI M100 in 2023: an explanatory review. Indian J Med Microbiol 46:100432. https://doi.org/10.1016/j.ijmmb.2023.100432
Poirel L, Walsh TR, Cuvillier V et al (2011) Multiplex PCR for detection of acquired carbapenemase genes. Diagn Microbiol Infect Dis 70(1):119–123. https://doi.org/10.1016/j.diagmicrobio.2010.12.002
Compain F, Babosan A, Brisse S et al (2014) Multiplex PCR for detection of seven virulence factors and K1/K2 capsular serotypes of Klebsiella pneumoniae. J Clin Microbiol 52(12):4377–4380. https://doi.org/10.1128/jcm.02316-14
Ranjbar R, Tabatabaee A, Behzadi P et al (2017) Enterobacterial repetitive intergenic consensus polymerase chain reaction (ERIC-PCR) genotyping of Escherichia coli strains isolated from different animal stool specimens. Iran J Pathol 12(1):25–34. https://doi.org/10.1016/j.bjm.2017.01.014
Hematzadeh A, Haghkhah M (2021) Biotyping of isolates of Pseudomonas aeruginosa isolated from human infections by RAPD and ERIC-PCR. Heliyon 7(9):e07967. https://doi.org/10.1016/j.heliyon.2021.e07967
Antimicrobial Resistance Collaborators (2022) Global burden of bacterial antimicrobial resistance in 2019: a systematic analysis. The Lancet 399(10325): 629–655. https://doi.org/10.1016/S0140-6736(21)02724-0
Pearson MA, Galas M, Corso A et al (2019) Latin American consensus to define categorize and report multidrug resistant, extensively drug-resistant, or pandrug-resistant pathogens. Rev Panam Salud Pública 43(e65):1–8. https://doi.org/10.26633/rpsp.2019.65
Hu FP, Yuan Ll, Yang Y et al (2022) A multicenter investigation of 2,773 cases of bloodstream infections based on China antimicrobial surveillance network (CHINET). Front Cell Infect Microbiol 12:1075185. https://doi.org/10.3389/fcimb.2022.1075185
Remya PA, Shanthi M, Sekar U (2019) Characterisation of virulence genes associated with pathogenicity in Klebsiella pneumoniae. Indian J Med Microbiol 37(2):210–218. https://doi.org/10.4103/ijmm.IJMM_19_157
Salud RP, Vargas MAM, Iglesias MAR et al (2023) Molecular characterization of consecutive isolates of OXA-48-producing Klebsiella pneumoniae: changes in the virulome using next-generation sequencing (NGS). Microbes Infect 25(8):105217. https://doi.org/10.1016/j.micinf.2023.105217
Li P, Luo WY, Xiang TX et al (2023) Isolation of Hv-CRKP with co-production of three carbapenemases (blaKPC, blaOXA-181 or OXA-232, and blaNDM-1) and a virulence plasmid: a study from a Chinese tertiary hospital. Front Microbiol 14(1182870):1–14. https://doi.org/10.3389/fmicb.2023.1182870
Bindayna KM, Joji RM, Ezzat H et al (2021) Genes conferring antimicrobial-resistance among Kllebsiella pneumoniae in the Arabian Gulf Coutries: a systermatic review and meta-analysis. Asian J Pharm Clin Res 14(4):90–99. https://doi.org/10.22159/ajpcr.2021.v14i4.40841
Wang, F, Dan, B, Hu, FP et al (2024). China Antimicrobial Surveillance Network (CHINET). http://www.chinets.com/Data/AntibioticDrugFast. Accessed March 13, 2024
Nassif X, Fournier JM, Arondel J et al (1989) Mucoid phenotype of Klebsiella pneumoniae is a plasmid-encoded virulence factor. Infect Immun 57(2):546–552. https://doi.org/10.1128/iai.57.2.546-552.1989
Yang XM, Liu XX, Chan EWC et al (2023) Functional Characterization of Plasmid-Borne rmpADC Homologues in Klebsiella pneumoniae. Microbiol Spectr 11(3):e03081–e03122. https://doi.org/10.1128/spectrum.03081-22
Lin CT, Wu CC, Chen YS et al (2011) Fur regulation of the capsular polysaccharide biosynthesis and iron-acquisition systems in Klebsiella pneumoniae CG43. Microbiology 157(2):419–429. https://doi.org/10.1099/mic.0.044065-0
Han RH, Niu M, Liu SM et al (2022) The effect of siderophore virulence genes entB and ybtS on the virulence of Carbapenem-resistant Klebsiella pneumoniae. Microb Pathog 171(105746):1–13. https://doi.org/10.1016/j.micpath.2022.105746
Hamam SS, Kholy RME, Zaki MES (2019) Study of various virulence genes, biofilm formation and extended-spectrum β-lactamase resistance in Klebsiella pneumoniae isolated from urinary tract infections. Open Microbiol J 13(1):249–255. https://doi.org/10.2174/1874285801913010249
Cubero M, Marti S, Domínguez M et al (2019) Hypervirulent Klebsiella pneumoniae serotype K1 clinical isolates form robust biofilms at the air-liquid interface. PLoS ONE 14(9):e0222628. https://doi.org/10.1371/journal.pone.0222628
Kuş H, Arslan U, Türk Dağı H et al (2017) Investigation of various virulence factors of Klebsiella pneumoniae strains isolated from nosocomial infections. Mikrobiyoloji bulteni 51(4):329–339. https://doi.org/10.5578/mb.59716
Ghamari M, Beigverdi R, Jabalameli F et al (2022) Antimicrobial resistance pattern, virulence determinants and molecular analysis of carbapenem-resistant Klebsiella pneumoniae isolated from clinical samples in Iran. FEMS Microbiol Lett 369(1):1–6. https://doi.org/10.1093/femsle/fnac100
Albasha AM, Osman EH, Abd-Alhalim S et al (2020) Detection of several carbapenems resistant and virulence genes in classical and hyper-virulent strains of Klebsiella pneumoniae isolated from hospitalized neonates and adults in Khartoum. BMC Res Notes 13(312):1–7. https://doi.org/10.1186/s13104-020-05157-4
Raheem A, Mohammad G (2021) Molecular Detection of Some Virulence Factors genes of Klebsiella pneumoniae Isolated from Food Samples. Annal Romanian Soc Cell Biol 25(4):11007–11019
Lam MMC, Wick RR, Wyres KL et al (2018) Genetic diversity, mobilisation and spread of the yersiniabactin-encoding mobile element ICEKp in Klebsiella pneumoniae populations. Microb Genom 4(9):e000196. https://doi.org/10.1099/mgen.0.000196
Wasfi R, Elkhatib WF, Ashour HM (2016) Molecular typing and virulence analysis of multidrug resistant Klebsiella pneumoniae clinical isolates recovered from Egyptian hospitals. Sci Rep 6(38929):1–11. https://doi.org/10.1038/srep38929
Zhang SH, Yang GZ, Ye QH et al (2018) Phenotypic and genotypic characterization of Klebsiella pneumoniae isolated from retail foods in China. Front Microbiol 9(289):1–11. https://doi.org/10.3389/fmicb.2018.00289
Elsayed ME, Abd El-Hamid MI, El-Gedawy A et al (2022) New insights into Listeria monocytogenes antimicrobial resistance, virulence attributes and their prospective correlation. Antibiotics 11(10):1447. https://doi.org/10.3390/antibiotics11101447
Shu G, Qiu JY, Zheng YL et al (2023) Association between phenotypes of antimicrobial resistance, ESBL resistance genes, and virulence genes of Salmonella isolated from chickens in Sichuan, China. Animal 13(17):2770. https://doi.org/10.3390/ani13172770
Chen G, Hou Y, Ye LY et al (2023) fbl-typing and Antimicrobial Resistance Analysis of Staphylococcus lugdunensis. Front Biosci-Landmark 28(8):165. https://doi.org/10.31083/J.FBL2808165
Doi Y, Paterson DL (2015) Carbapenemase-Producing Enterobacteriaceae. Semin Respir Crit Care Med 36(01):74–84. https://doi.org/10.1055/s-0035-1544208
Liu Z, Gu Y, Li X et al (2019) Identification and characterization of NDM-1-producing hypervirulent (Hypermucoviscous) Klebsiella pneumoniae in China. Ann Lab Med 39(2):167–175. https://doi.org/10.3343/alm.2019.39.2.167
Dong N, Sun Q, Huang Y et al (2019) Evolution of carbapenem-Resistant serotype K1 hypervirulent Klebsiella pneumoniae by acquisition of blaVIM-1-bearing plasmid. Antimicrob Agent Chemother 63(9):e01056–e01119. https://doi.org/10.1128/aac.01056-19
Volozhantsev NV, Shpirt AM, Kislichkina AA et al (2020) Structure and gene cluster of the capsular polysaccharide of multidrug resistant carbapenemase OXA-48-producing Klebsiella pneumoniae strain KPB536 of the genetic line ST147. Res Microbiol 171(2):74–79. https://doi.org/10.1016/j.resmic.2019.10.001
Yu WL, Ko WC, Cheng KC et al (2006) Association between rmpA and magA genes and clinical syndromes caused by Klebsiella pneumoniae in Taiwan. Clin Infect Dis 42(10):1351–1358
Klebba PE, Newton SMC, Six DA et al (2021) Iron acquisition systems of gram-negative bacterial pathogens define TonB-dependent pathways to novel antibiotics. Chem Rev 121(9):5193–5239. https://doi.org/10.1021/acs.chemrev.0c01005
Maleki NS, Babazadeh F, Arzanlou M et al (2023) Serotyping and molecular profiles of virulence-associated genes among Klebsiella pneumoniae isolates from teaching hospitals of Ardabil, Iran: a cross-sectional study. Health Sci Rep 6(9):e1557. https://doi.org/10.1002/hsr2.1557
Stahlhut SG, Struve C, Krogfelt KA et al (2012) Biofilm formation of Klebsiella pneumoniae on urethral catheters requires either type 1 or type 3 fimbriae. FEMS Immunol Med Microbiol 65(2):350–359. https://doi.org/10.1111/j.1574-695X.2012.00965.x
Li Y, Han WY, Li ZJ et al (2009) Klebsiella pneumoniae MrkD adhesin-mediated immunity to respiratory infection and mapping the antigenic epitope by phage display library. Microb Pathog 46(3):144–149. https://doi.org/10.1016/j.micpath.2008.11.006
Acknowledgements
Great appreciation is given to all members of our laboratory for their enthusiastic participation in the research.
Funding
This work was supported by the Special Projects in Key Areas of Colleges and Universities in Guangdong Province (2023ZDZX2031); the Guangdong Province College Students’ Innovation and Entrepreneurship Training Program (202210573045, 202310573022).
Author information
Authors and Affiliations
Contributions
SLB and YLH: conceived the study, YLH, ZYZ and NQK: performed material preparation and data collection, YLH: performed analysis and drafted the manuscript. And all authors commented on previous versions of the manuscript. All authors approved the final manuscript.
Corresponding author
Ethics declarations
Conflict of interest
The authors have no conflict of interest to declare.
Ethical Approval
Not applicable.
Consent to Participate
Not applicable.
Consent for Publication
Not applicable.
Additional information
Publisher's Note
Springer Nature remains neutral with regard to jurisdictional claims in published maps and institutional affiliations.
Supplementary Information
Below is the link to the electronic supplementary material.
Rights and permissions
Springer Nature or its licensor (e.g. a society or other partner) holds exclusive rights to this article under a publishing agreement with the author(s) or other rightsholder(s); author self-archiving of the accepted manuscript version of this article is solely governed by the terms of such publishing agreement and applicable law.
About this article
Cite this article
Hu, YL., Bi, SL., Zhang, ZY. et al. Correlation between Antibiotics-Resistance, Virulence Genes and Genotypes among Klebsiella pneumoniae Clinical Strains Isolated in Guangzhou, China. Curr Microbiol 81, 289 (2024). https://doi.org/10.1007/s00284-024-03818-2
Received:
Accepted:
Published:
DOI: https://doi.org/10.1007/s00284-024-03818-2